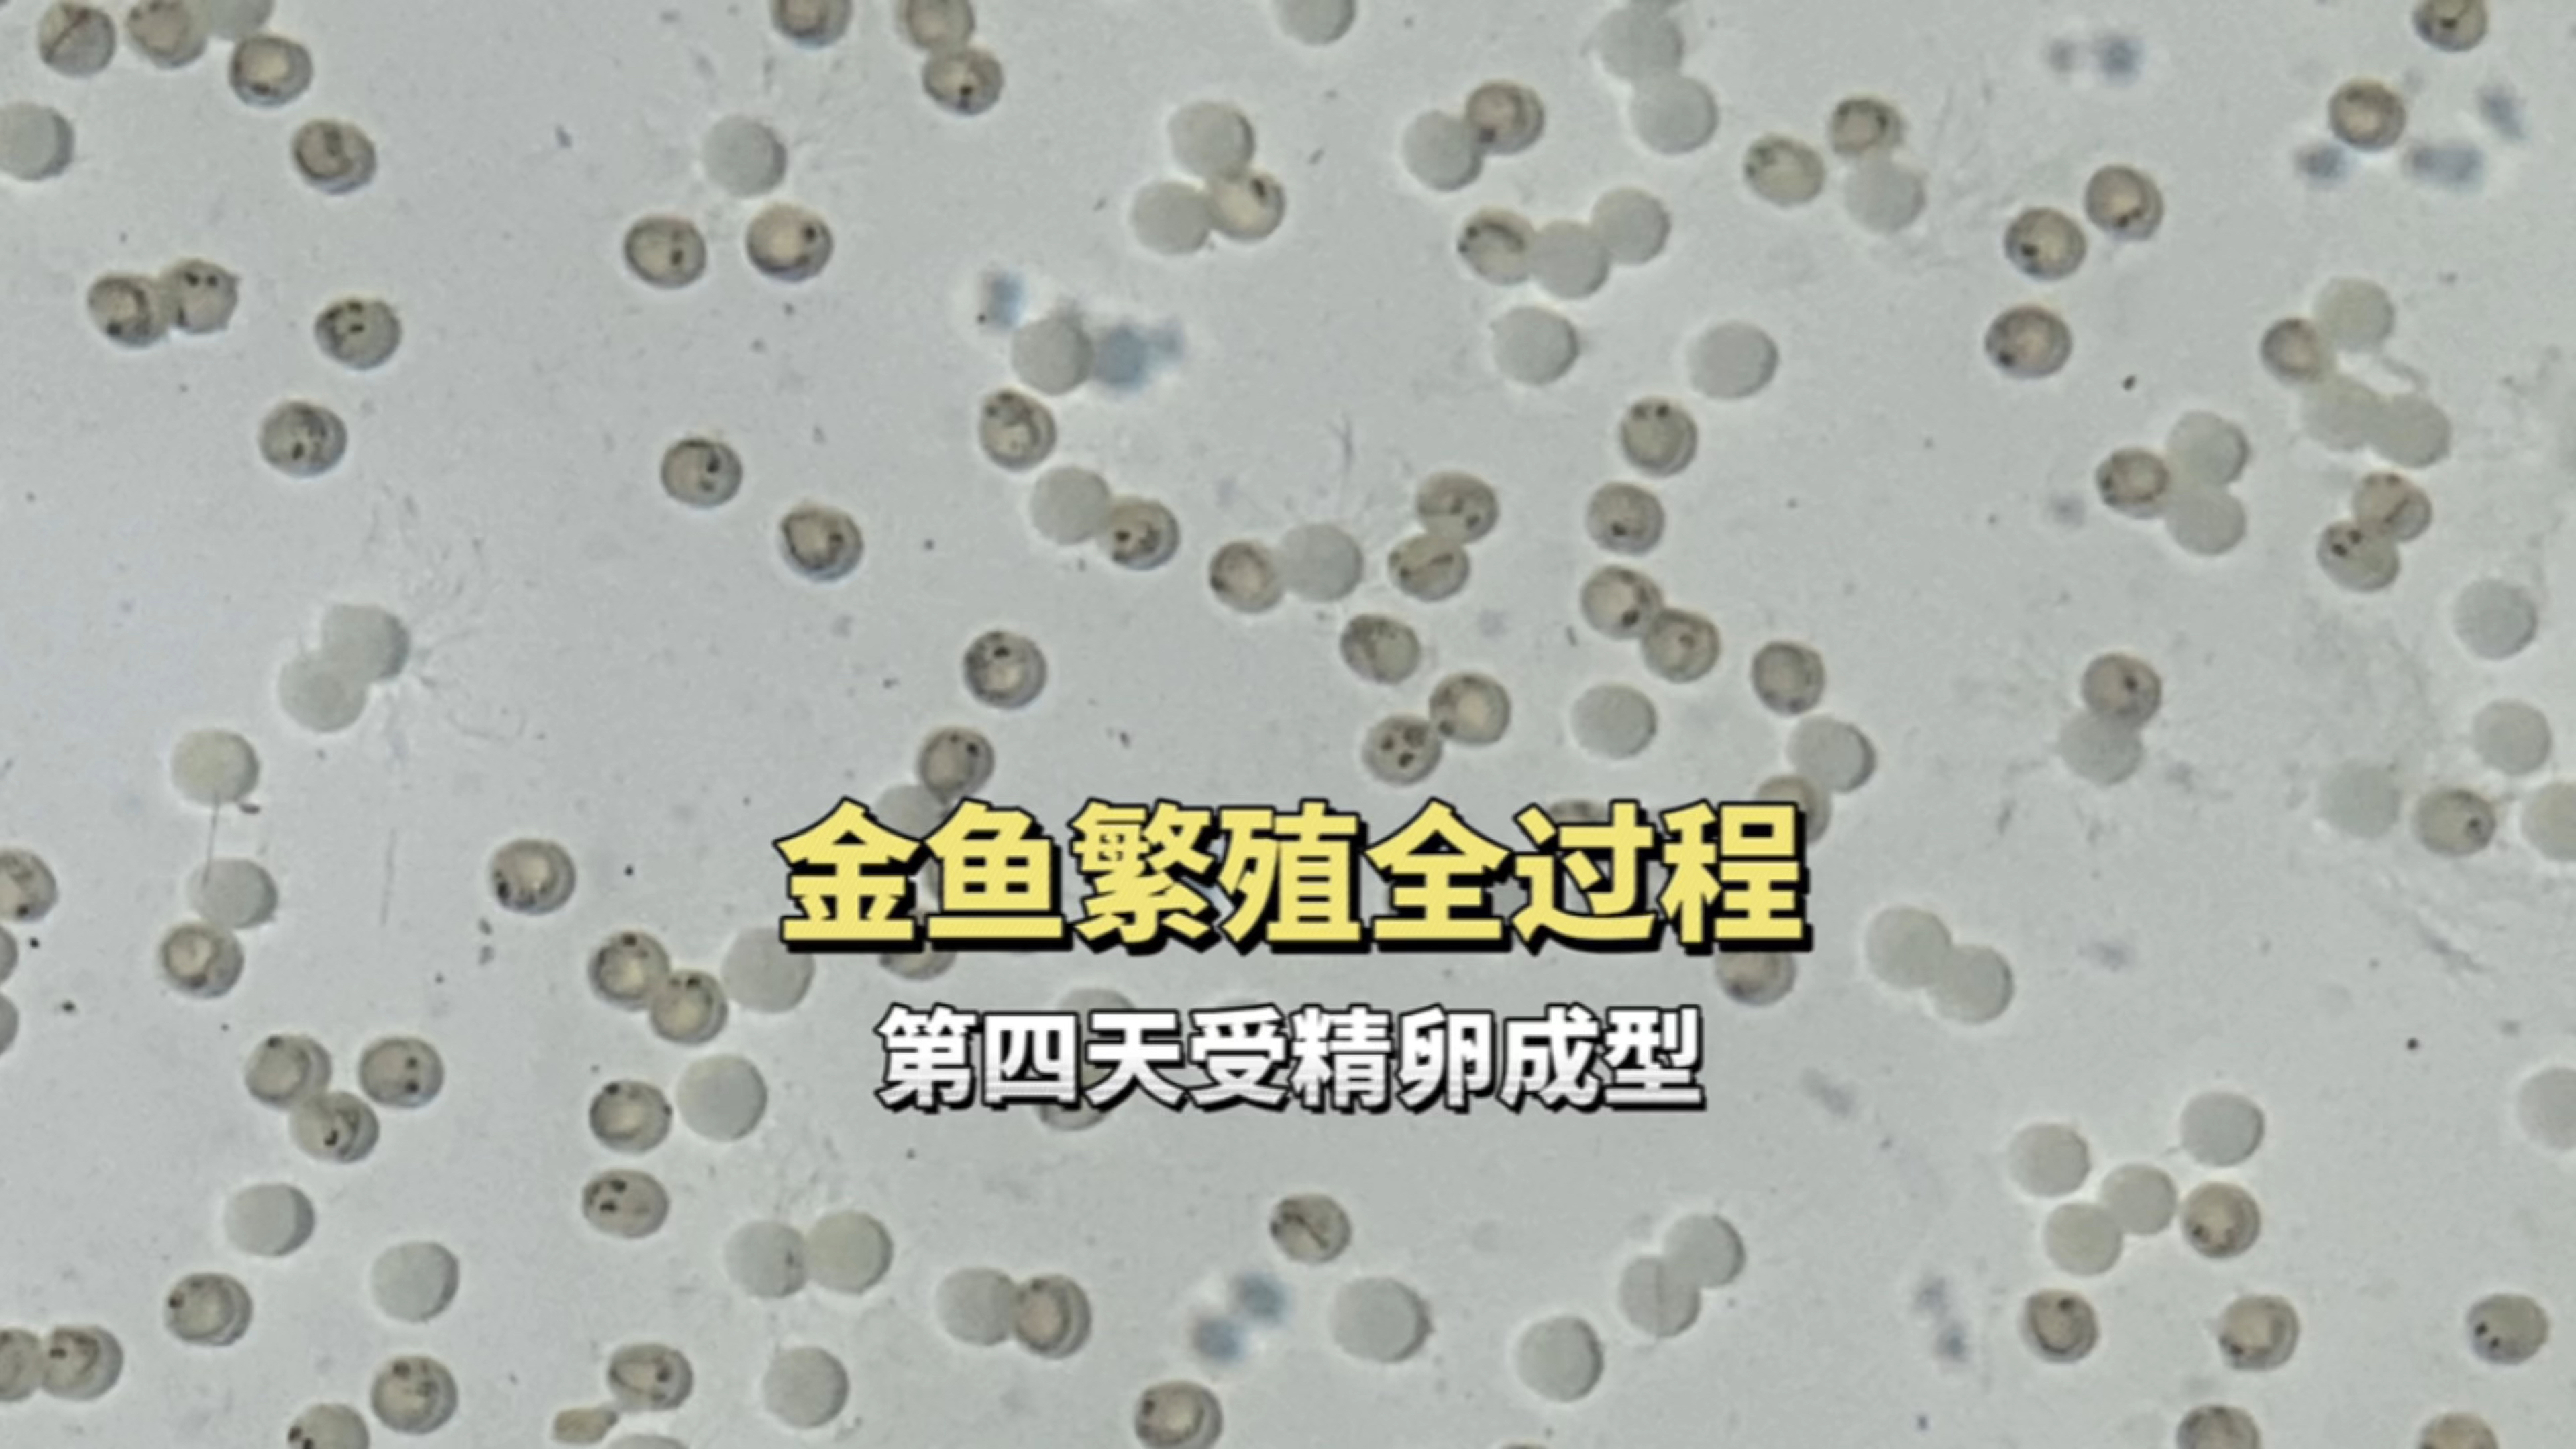
金鱼繁殖的全过程,第四天受精卵像小蝌蚪,金鱼圈的乱象

金鱼卵是什么样子图片相关视频
金鱼排卵图片
金鱼屎是什么样子图片
金鱼卵是什么样子
鱼卵刚产下的图片
金鱼什么时候产卵
金鱼卵刚产下的图片
锦鲤鱼卵刚产下的图片
小鱼生的卵的图片
金鱼卵的孵化过程
金鱼屎
金鱼产卵过程
草金鱼卵图片
金鱼卵是什么样子图片视频列表
-
01:18
金鱼卵孵化全过程揭秘,从受精到游动只需五天 用户:狸狸划水中 -
02:25
金鱼繁殖的全过程,第四天受精卵像小蝌蚪,金鱼圈的乱象 用户:正水少一
02:25
金鱼繁殖的全过程,第四天受精卵像小蝌蚪,金鱼圈的乱象 用户:正水少一 -
00:43
金鱼卵的颜色是怎么来的? 用户:爱养鱼的大刘刘